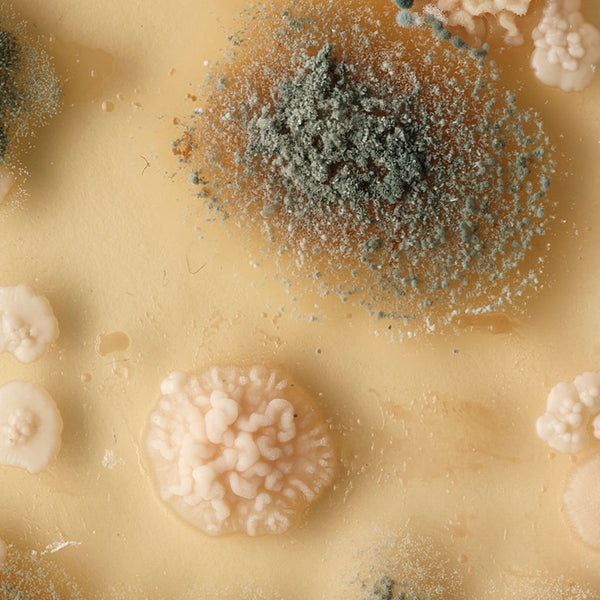

Where design meets renewal.
Every system in nature runs in circles, nothing wasted, everything renewed. Footwear designed on purpose from day one, so that their last act is to give back. That’s what we call Biocircularity: from natural materials to shoemaking craft, from shredding machines to the rocket composter, every step is thought through. The result: shoes that live well with you, then return safely to the earth.
Our System
Sourced
Selecting nature-safe materials that are durable, beautiful, and safe for compost.
Crafted
Shoes built in our own factory, with craft, care, and no harmful plastics or chemicals.
Worn
Designed for real life: miles, rain, and everyday wear. Compost-capable doesn’t mean fragile.
Returned
When their journey ends, send them back through our system.
Unmade
Our shredder tears them down so microbes can build them back up.
Cultured
Mixed with horse manure, grass, and coffee grounds to feed the microbes.
Controlled
In the rocket composter, heat, air, and patience transform the mix.
Earthed
The result: nutrient-rich compost that meets industry standards.
Sourced
Crafted
Worn
Returned
Unmade
Cultured
Controlled
Earthed








Materials chosen for endings as well as beginnings.
We don’t just ask, “Will this material perform in a shoe?” We ask, “What will happen when it’s done?” That’s why every SOLK starts with resources like chrome-free leathers, natural rubber, plant based fibers, and Made to Fade foams, all proven to break down safely. For us, sourcing is already part of the end-of-life plan.
Shoemaking under one roof.
Most brands spread production across multiple factories, none of which they own or operate. We chose to build in our own. That way we control every stitch, every glue line, every condition. Some of our machines are very traditional, artisanal even, others super modern. It’s the fusion of old and new world that creates the right balance for precision, craft and consistency. It’s more challenging to create products this way but it means we know exactly how each pair of shoes is built & what it’s built out of.
Footwear for real life.
Compostable doesn’t mean delicate. SOLKs are made to handle rain, miles, and the scuffs of daily life. What sets them apart is not fragility, but foresight: built for your today, designed with tomorrow in mind.
Closing the loop together.
When your SOLKs have done their miles, sending them back isn’t an afterthought. It’s the most important step in the cycle. Without return, the loop stays open. With it, we take full responsibility for what we’ve made.
The shredder stage.
Here’s where the real transformation begins. Worn shoes are fed into a high-torque shredder that rips them into pieces within seconds. The ragged edges it creates are not a flaw. They’re essential. Microbes latch onto these rough surfaces, finding more places to start their work.
The messy magic mix.
The shredded shoes are blended with organic matter. Horse manure, meadow clippings, and coffee grounds become accelerators, feeding microbes and balancing the carbon-to-nitrogen ratio. This isn’t random: every mix is calibrated, stirred, and tested until it’s ready to thrive in the next stage.
The rocket composter.
This is where biology meets engineering. Inside the rocket composter, our slurry is kept at optimal temperature and airflow. It’s not just about waiting. It’s carefully managed with sensors that track heat, oxygen, and moisture. At 60+ °C, pathogens are destroyed while beneficial microbes thrive. Over days and weeks, footwear is transformed into something new: nutrient-rich pre-compost.
Tested, nutricious compost.
The circle ends where it began, in the ground. Our home-cured SOLK-slurry can now be blended into industrial composting.The output is not waste but living compost, tested against industry standards for safety and nutrient content. What began as a shoe becomes compost that can grow new life. Loop closed.